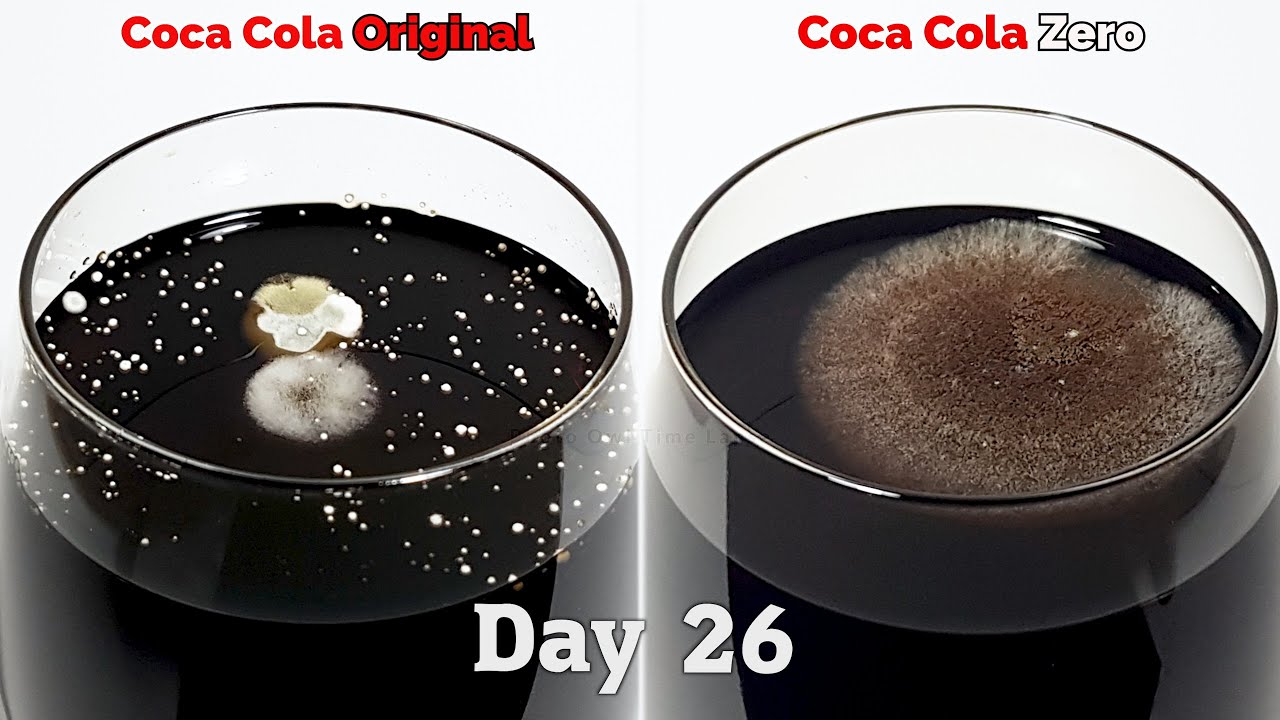

コカ・コーラとコカ・コーラゼロを102日間放置し、腐敗していく様子を記録したタイムラプス。
最初の数日はどちらも同じ量の水分が減るだけ。
しかし10日目からはカビのようなものが見え始めます。
100日目を経過するころ、普通のコーラにはガムシロップのようなものが残留。
ゼロカロリーのほうは完全に蒸発しています。
左側が通常のコーラ、右側にコカ・コーラ ゼロ、左下に経過時間が表示されています。
どれくらいの湿度と温度で観察したのかが気になりますね。
科学
科学コカ・コーラとコカ・コーラゼロを102日間放置し、腐敗していく様子を記録したタイムラプス。
最初の数日はどちらも同じ量の水分が減るだけ。
しかし10日目からはカビのようなものが見え始めます。
100日目を経過するころ、普通のコーラにはガムシロップのようなものが残留。
ゼロカロリーのほうは完全に蒸発しています。
左側が通常のコーラ、右側にコカ・コーラ ゼロ、左下に経過時間が表示されています。
どれくらいの湿度と温度で観察したのかが気になりますね。
コメント